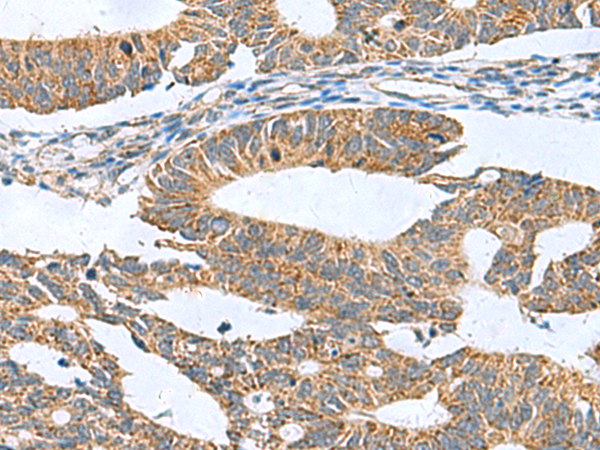

|
Background: |
Natural killer (NK) cells express multiple calcium-dependent (C-type) lectin-like receptors, such as CD94 (KLRD1; MIM 602894) and NKG2D (KLRC4; MIM 602893), that interact with major histocompatibility complex class I molecules and either inhibit or activate cytotoxicity and cytokine secretion. CLEC2 is a C-type lectin-like receptor expressed in myeloid cells and NK cells (Colonna et al., 2000 [PubMed 10671229]). |
|
Applications: |
ELISA, IHC |
|
Name of antibody: |
CLEC1B |
|
Immunogen: |
Fusion protein of human CLEC1B |
|
Full name: |
C-type lectin domain family 1 member B |
|
Synonyms: |
CLEC2; CLEC2B; PRO1384; QDED721; 1810061I13Rik |
|
SwissProt: |
Q9P126 |
|
ELISA Recommended dilution: |
5000-10000 |
|
IHC positive control: |
Human colorectal cancer and Human liver cancer |
|
IHC Recommend dilution: |
50-200 |

購(gòu)物車(chē)
購(gòu)物車(chē) 幫助
幫助
 021-54845833/15800441009
021-54845833/15800441009
